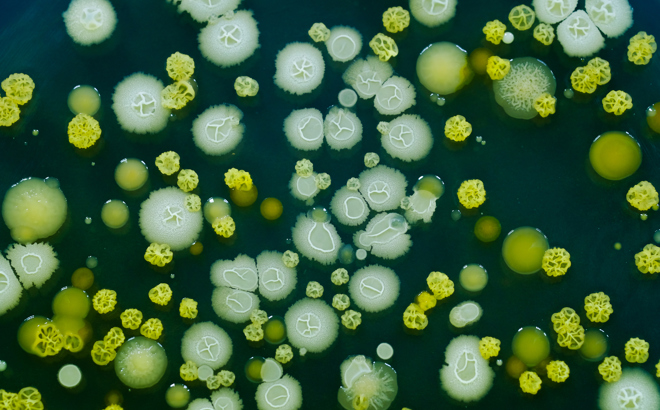

What is food contamination?
Food contamination is a general term, but what does it really mean? Why does it happen, and how can it affect your health? Simply put, all food is at risk of contamination. Most cases fall into one of three categories:
- Chemical
- Physical
- Biological
Before going further, it is important to discuss food safety. The Covid-19 pandemic has led to the concept of food safety becoming more widespread and more strictly enforced. There is now greater awareness that the dangers come in many forms, both natural elements and foreign contaminants.
Therefore, safe food handling practices and procedures must be implemented across the chain of production and processing.